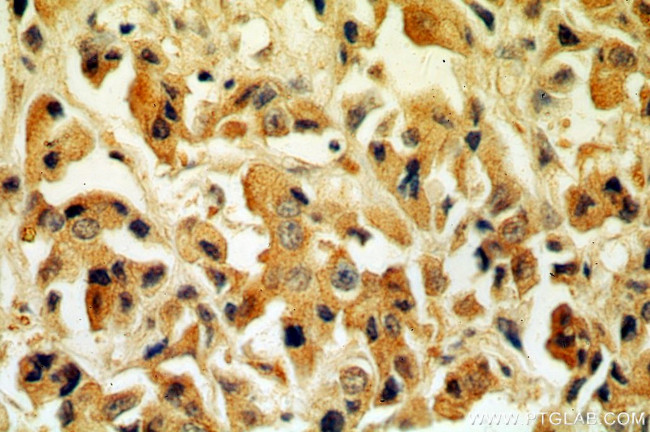
Tenascin-X Antibody in Immunohistochemistry (Paraffin) (IHC (P))

Search
Proteintech
Tenascin-X Polyclonal Antibody
{{$productOrderCtrl.translations['antibody.pdp.commerceCard.promotion.promotions']}}
{{$productOrderCtrl.translations['antibody.pdp.commerceCard.promotion.viewpromo']}}
{{$productOrderCtrl.translations['antibody.pdp.commerceCard.promotion.promocode']}}: {{promo.promoCode}} {{promo.promoTitle}} {{promo.promoDescription}}. {{$productOrderCtrl.translations['antibody.pdp.commerceCard.promotion.learnmore']}}
产品信息
13595-1-AP
已发表种属
宿主/亚型
分类
类型
抗原
偶联物
形式
浓度
规格
保存条件
运输条件
产品详细信息
This antibody is raised against human TNXB and detects a band about 75 kDa, which probably represent a proteolytic cleaved form of human TNXB.
靶标信息
Tenascin-X (TNXB) is a extracellular matrix glycoprotein predominantly located in the outer reticular lamina of the basement membrane (BM). It interacts with many other ECM proteins and it accelerates collagen fibrillogenesisin vitro. TNXB plays a role in interactions between cell and ECM, antiadhesive effect, inhibiting cell migration, and in maintaining homeostasis of the extracellular matrix. Deficiency of TNXB has been associated with the connective tissue disorder Ehlers-Danlos syndrome.
仅用于科研。不用于诊断过程。未经明确授权不得转售。